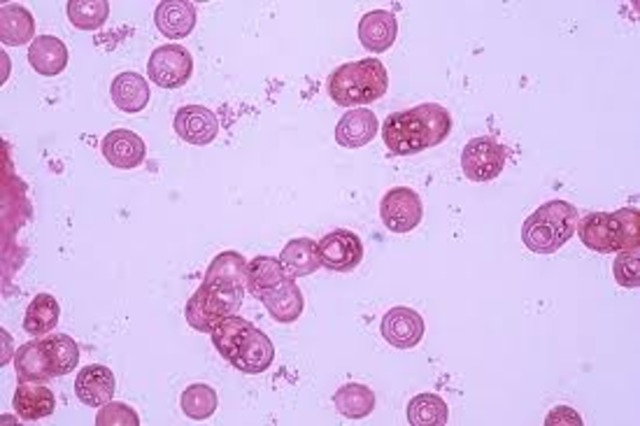
Se descubren las enzimas de restricción en la bacteria Haemophilius influenzae

-
se descubre la celula
-
Charles Darwin, publica en el origen de la especie - su explicación de la evolución por la selección natural.
-
Se publica el trabajo de Gregor Mendel
-
Gregor Mendel publica su trabajo sobre los patrones de la herencia en plantas de guisante.
-
1900 Los botánicos Hugo de Vries, Carl Correns y Eric Von Tschermak redescubren el trabajo de Gregor Mendel
-
Se descubre la implicación de los cromosomas en la herencia
-
Thomas Hunt Morgan demuestra que los genes residen en los cromosomas
-
Alfred Sturtevant crea el primer mapa genético de un cromosoma
-
1923 Los mapas genéticos demuestran la disposición lineal de los genes en los cromosomas
-
Los estudios demuestran que las radiografías pueden inducir mutaciones en el material genético
-
Se denomina mutación a cualquier cambio en la secuencia nucleotídica de un gen, sea esta evidente o no en el fenotipo
-
Se descubren las propiedades antibióticas de la penicilina: Alexander Fleming
-
Fred Griffith descubre una molécula hereditaria transmisible entre bacterias
-
El entrecruzamiento es la causa de la recombinación
-
Edward Lawrie Tatum y George Wells Beadle demuestran que los genes codifican proteínas
-
Oswald Theodore Avery, Colin McLeod y Maclyn McCarty demuestran que el ADN es el material genético
-
Erwin Chargaff demuestra que las proporciones de cada nucleótido siguen algunas reglas (por ejemplo, que la cantidad de adenina, A, tiende a ser igual a la cantida de timina, T). Barbara McClintock descubre los transposones en el maíz
-
1952 El experimento de Hershey y Chase demuestra que la información genética de los fagos reside en el ADN
-
1953 James D. Watson y Francis Crick determinan que la estructura del ADN es una doble hélice
-
Jo Hin Tjio y Albert Levan establecen que, en la especie humana, el número de cromosomas es 46
-
1958 El experimento de Meselson y Stahl demuestra que la replicación del ADN es semiconservativa
-
El código genético está organizado en tripletes
-
el genetista surafricano Sydney Brenner divulgan que los tríos de la DNA basan - los nucleótidos llamados - cada asimiento las instrucciones para uno de los 20 aminoácidos que combinan para formar las proteínas
-
Se descubren las enzimas de restricción en la bacteria Haemophilius influenzae, lo que permite a los científicos manipular el ADN
-
Fred Sanger, Walter Gilbert, y Allan Maxam secuencian ADN por primera vez trabajando independientemente.
-
Las bacterias genético modificadas producen la insulina de la hormona
-
Kary Banks Mullis descubre la reacción en cadena de la polimerasa, que posibilita la amplificación del ADN
-
Francis Collins y Lap-Chee Tsui secuencian un gen humano por primera vez. El gen codifica la proteína CFTR, cuyo defecto causa fibrosis quística
-
El proyecto de genoma humano internacional comienza, con la meta de ordenar el código genético humano entero
-
Se da a conocer por primera vez la secuencia completa de un eucariota, la levadura Saccharomyces cerevisiae
-
Clonación del primer animal a apartar de una célula adulta la oveja Dolly
-
Se da a conocer por primera vez la secuencia completa de un eucariota pluricelular
-
El Proyecto Genoma Humano y Celera Genomics presentan el primer borrador de la secuencia del genoma humano
-
Se completa con éxito el Proyecto Genoma Humano con el 99% del genoma secuenciado con una precisión del 99,99%
-
Se cultivaron 90 millones de hectáreas con cultivos genéticamente modificados en 21 países
-
Se realizan reformas al Reglamento de la Ley de Bioseguridad de Organismos Genéticamente Modificados que adicionan al Régimen de Protección Especial al Maíz.
-
En México se sembraron 85,000 hectáreas de algodón genéticamente modificado en fase experimental
-
los robots son llevados al mercado como una unidad general de construcción y mantenimiento
-
será posible vivir 5000 años Puede que las generaciones que pisamos hoy la Tierra seamos las últimas que conozcamos la muerte, ya que la medicina regenerativa, la investigación genética y la biotecnológica nos auguran la longevidad radical,
El proceso será gradual, ya que los niños de hoy serán testigos del final de la diabetes, del Parkinson, del Alzheimer o del cáncer y vivirán seguramente hasta 150 años.
Want to make a timeline like this?
Use Timetoast to turn dates, events, milestones, and phases into a clear visual timeline you can build and share. Timetoast is a timeline maker for work, school, research, and stories.